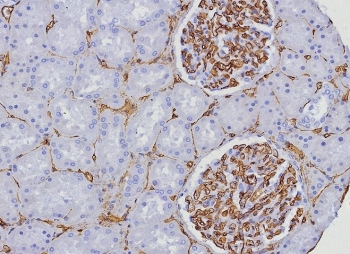
CD34 Antibody

You have no items in your shopping cart.
Search results for: 'antibody'
- VEGF Antibody / Vascular Endothelial Growth Factor [orb1823262]
IHC-P
Human
Rabbit
Recombinant
Unconjugated
100 μg, 20 μg - VEGF Antibody / Vascular Endothelial Growth Factor [orb1823264]
IHC-P
Human
Rabbit
Recombinant
Unconjugated
100 μg - VEGF Antibody / Vascular Endothelial Growth Factor [orb1823265]
IHC-P
Human
Rabbit
Recombinant
Unconjugated
100 μg, 20 μg - VEGF Antibody / Vascular Endothelial Growth Factor [orb1823261]
IHC-P
Human
Rabbit
Recombinant
Unconjugated
100 μg - TP63 Antibody / Tumor protein 63 / p63 [orb1823523]
IHC-P
Human
Rabbit
Recombinant
Unconjugated
20 μg, 100 μg